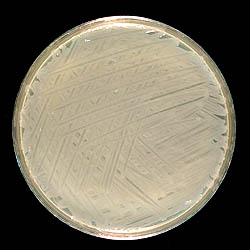

This laboratory exercise focuses on the use of electroporation for the transformation of Pseudomonas syringae pv. syringae strain B301D with a broad host range plasmid. Two broad host range plasmids are listed, and either one can be used. Plasmid pRK415 is larger than pUCP26 and will exhibit a lower efficiency of transformation than pUCP26.MATERIALS:
MEDIA
CLICK HERE FOR MEDIA RECIPES:
Bacterial strain
Plasmid DNA
-
pRK415, an RK2-derived broad host range vector, 13 kb in size, Tcr (6).
-
pUCP26, a pUC-derived vector, 4.9 kb in size, carrying the 1.9-kb PstI fragment enabling the plasmid to be maintained in Pseudomonas, Tcr (13).
Equipment
- Micropipetors (1000 µl, 250 µl, and 25 µl capacity)
-
Sterile pipet tips
-
Gene Pulser II electroporation system with Pulse Controller II Unit (Bio-Rad Laboratories, Hercules, CA)
-
Cuvettes (0.1 cm) (store these at -20ºC and keep on ice until you are ready to use them)
CLICK HERE FOR Instructor's Note 1
-
Sterile glass test tubes.
-
Shaking incubator (25°C)
-
Glass hockey stick for spreading bacteria
-
Microfuge tubes (1.5 and 0.5 ml capacity)
-
Sterile distilled water.
CLICK HERE FOR Instructor's Note 2
PROCEDURE:
1. Inoculate an NBY plate with freshly growing cells of P. syringae pv. syringae strain B301D (<24 h old) using a sterile loop, so that a lawn of bacteria will grow. Incubate the petri plate at 25°C overnight (~16 h). The bacteria should be in exponential to early stationary phase. Using bacterial cells in late stationary phase can reduce the efficiency of electroporation; therefore, cultures greater than 24-h old should not be used.
|
| Figure 1. Bacterial lawn of P. syringae pv. syringae strain B301D. The NBY plate was inoculated with the bacterial strain B301D and incubated at 25ºC for ~ 16 h. |
2. Resuspend the bacterial lawn using 4 ml of cold sterile distilled water (SDW). Be careful not to resuspend small pieces of agar, because the presence of agar in the bacterial suspension will decrease the electroporation efficiency. It is important to keep the bacterial cells on ice throughout the procedure to increase the electroporation efficiency.
3. Transfer the suspension to 1.5 ml microfuge tubes and pellet the cells (14,000 rpm for 1 min).
4. Resuspend each microfuge tube of cells in 1 ml cold SDW and repeat step 3 twice. After the second wash, resuspend the cells in ~400 µl of cold SDW for each petri plate of cells and place the microfuge tube of cells on ice. Remove a 5 µl aliquot and determine the cell concentration by dilution plating.
CLICK HERE FOR Instructor's Note 3
5. Electroporator settings: capacitance=200
, voltage=1.8 kV/cm.
6. Pipet 60 µl of bacterial cells into a 0.5 ml microfuge tube with 100-500 ng of plasmid pRK415 or pUCP26 DNA and mix gently.
7. Pipet bacterial cells and the DNA suspension into an electroporation cuvette and electroporate.
CLICK HERE FOR Instructor's Note 4
8. Dilute the electroporation mix with 1 ml of SOC and place it in a test tube with 4 ml of SOC. Incubate with shaking at 25°C for 4 h.
9. Remove 1 ml aliquots and pellet the entire 5 ml culture in 1.5 ml microfuge tubes (14,000 rpm for 1 min)
10. Resuspend the bacterial cells in 200 µl of NBY broth per microfuge tube. Transfer 100 µl aliquots onto NBY agar plus appropriate selection (i.e., Tc for pRK415 and pUCP26) and spread evenly across the agar surface using a sterile glass hockey stick. Incubate the petri plates at 25°C for 48 h.
11. Pick colonies that grow after 48 h and streak for single colonies onto NBY agar plus appropriate selection to confirm transformation. Incubate the petri plates at 25°C for 48 h.
12. Colonies that grow and are Tcr should carry the broad host range plasmid. Confirm the presence of the plasmid within these colonies by isolating plasmid DNA and checking it on agarose gels.
CLICK HERE FOR Instructor's Note 5
OBSERVATIONS:
Calculate the electroporation frequency for each plasmid. This is reported as transformants/µg DNA.
Efficiencies of transformation can vary but generally an electroporation efficiency of 1 x 105 transformants/µg DNA is attained for pUCP26 and an electroporation efficiency of 1 x 104 transformants/µg DNA is attained for pRK415, when electroporated into P. syringae pv. syringae strain B301D.
QUESTIONS FOR DISCUSSION:
-
How does plasmid size affect the electroporation efficiency?
-
What are some alternatives to using electroporation for the introduction of a broad host range plasmid into P. syringae pv. syringae strain B301D?
CLICK HERE FOR Instructor's Note 6